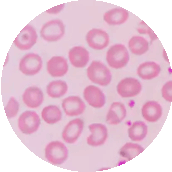

Ictericia
El color amarillento en la piel y su relación con la bilirrubina
¿Que es ictericia?
La ictericia es una afección que se manifiesta por el color amarillento en la piel y la parte blanca del ojo. Incluso tus fluidos corporales pueden ser amarillos. El color que pueda tener tu piel y la parte blanca de tu ojo varía en función de tus niveles de bilirrubina, una sustancia que se encuentra en la sangre. Los niveles moderados de la misma en el cuerpo dan lugar a un color amarillo, mientras que los niveles muy altos dan lugar a un color marrón. Puedes desarrollar ictericia desde la infancia hasta la edad adulta. Suele ser un signo de que tienes alguna enfermedad coexistente en el organismo (en el hígado, el intestino o el conducto biliar).
Ictericia neonatal
La ictericia neonatal se produce por un exceso de bilirrubina en la sangre, un componente amarillo de los glóbulos rojos. La ictericia neonatal es muy frecuente en los recién nacidos, sobre todo en los prematuros y en los que son amamantados. La ictericia no siempre requiere tratamiento
Hay tres tipos de ictericia:
- Ictericia hepatocelular: debido que tienes una enfermedad o lesión hepática
- ictericia hemolítica: debido que has tenido un aumento de la producción de bilirrubina
- Ictericia obstructiva: debido a que tienes una obstrucción en tu conducto biliar
ICTERICIA
Causas de ictericia
Si tienes una alteración de la función de la bilirrubina en la sangre, se dice que desarrollaste ictericia. Hay muchas causas posibles de ictericia en los adultos, algunas de las cuales son muy graves.
![Cálculo en la vesícula biliar]()
Cálculo en la vesícula biliar
![Pancreatitis]()
Pancreatitis
![Hepatitis]()
Hepatitis
![Anemia falciforme]()
Anemia falciforme
El hígado produce bilis, una enzima que ayuda a la digestión. La bilirrubina conjugada entra en la bilis y se elimina del organismo. Este tipo de bilirrubina es la que da el color marrón a tus heces. Si tienes mucha bilirrubina, ésta se difunde en los tejidos circundantes. Esto se conoce como hiperbilirrubinemia y es responsable de que tus ojos y piel adquieran un color amarillo.
La ictericia neonatal se manifiesta con un color amarillo en la piel del bebé y en la parte blanca del ojo. Se produce entre el segundo y el cuarto día de nacimiento. Muchos recién nacidos desarrollan ictericia. En algunos casos, otro trastorno en el organismo del bebé, como una infección bacteriana o vírica, una hemorragia interna, una infección sanguínea, una disfunción hepática, una incompatibilidad entre la sangre de la madre y la del bebé o la falta de una enzima, puede ser el responsable de la ictericia.
Cuando eres adulto, este padecimiento también se manifiesta con el amarillamiento de la piel y el blanco de los ojos. Suele comenzar en la cabeza y se puede extender al resto de tu cuerpo. Otros síntomas son heces pálidas, picores y orina de color oscuro. En caso de que tengas un nivel bajo de bilirrubina puedes tener una pérdida de peso, náuseas, dolor pélvico y fatiga.
Diagnostico de ictericia
Para que puedas ser diagnosticado con ictericia, se requiere que te hagas un examen clínico por parte de tu médico, que es un gastroenterólogo. Es muy importante que registres tu historial médico y tus pruebas de laboratorio. Es importante que te examinen el hígado y la zona abdominal para determinar si tienes algún riesgo de cirrosis o cáncer. Se recomienda que te realices pruebas de la función hepática y análisis de sangre para medir tus niveles de bilirrubina.
Algunas de las pruebas que probablemente te soliciten son:
- Medición de la bilirrubina en sangre
- Un análisis de sangre general
- Prueba de anticuerpos contra la hepatitis A, B y C.
- Además, y a petición del médico, puede ser necesario que te hagas una investigación adicional mediante radiografía, ecografía o resonancia magnética.
En el caso de la ictericia neonatal, el diagnóstico suele hacerse por el cuadro clínico del recién nacido, es decir, se evidencia en el color de la piel. El pediatra examinará al recién nacido bajo una luz brillante para ver si hay ictericia. En cualquier caso, debe confirmarse mediante análisis de sangre que incluyan la medición de la bilirrubina.
Ictericia: tratamiento
En el caso de que desarrolles ictericia ya siendo adulto, el tratamiento dependerá de lo que te esté causando ictericia. Si se debe a que padezcas anemia, tu médico te recetará tomar un suplemento de hierro y llevar una dieta rica en hierro. Si se debe a que tienes una infección por hepatitis, se te administrará un tratamiento antiviral adecuado a tu caso o deberás tomar medicación con esteroides. Si has desarrollado ictericia debido a que tienes un tumor canceroso, es necesaria la extirpación quirúrgica. Si la causa es que tomas determinados medicamentos, tu médico probablemente sustituirá el medicamento por otro.
Si has desarrollado ictericia debido a una estenosis de las vías biliares, se te recomendarán nuevos métodos que han sustituido a la cirugía clásica, la CPRE (colangiopancreatografía retrógrada endoscópica) y la EUS (ecografía endoscópica). Durante estos procedimientos, el gastroenterólogo especialista te colocará una endoprótesis para drenar la bilis hacia tu intestino delgado. Es importante que tu médico te informe antes del procedimiento sobre la preparación especial que debes de llevar, y sobre lo que debes tener en cuenta antes del examen y el procedimiento programado.
La ictericia neonatal no siempre necesita tratamiento. En algunos casos se resuelve por sí solo en 2-3 semanas. En caso de ictericia moderada o más grave, el recién nacido debe permanecer en la sala de maternidad el tiempo que prescriba el médico que lo atiende. Los tratamientos existentes para reducir el nivel de bilirrubina en la sangre son la fototerapia (se coloca al bebé bajo una lámpara especial; se requiere la protección de los ojos del niño con gafas especiales), en algunos casos en los que la ictericia está asociada a la diferenciación del grupo sanguíneo de la madre con el del recién nacido, puede aplicarse una medicación proteica destinada a reducir el nivel de anticuerpos en el organismo, y en casos más graves y raros en los que el recién nacido no responde a ningún otro tratamiento, será necesario aplicarle una transfusión de sangre.
Costo del tratamiento de la ictericia
El costo del tratamiento de la ictericia depende de la causa y del tratamiento que debas de recibir. El médico encargado de tratar la ictericia en los adultos es el gastroenterólogo, mientras que en los neonatos es el pediatra. Por lo general, el diagnóstico se realiza en la sala de maternidad y el bebé puede ser hospitalizado durante varios días.
El costo aproximado de la consulta general por pediatría: $750 MXN - $1,000 MXN
El costo aproximado de la consulta general por gastroenterología: $900 MXN - $1,300 MXN
Consejos sobre la ictericia
¡Todo con moderación y sin excesos!
La ictericia está relacionada con la función hepática. Esto significa que es importante que mantengas la salud de tu hígado en buen estado.
Come sano
Una dieta equilibrada te ayudará a que tu hígado funcione correctamente, lo que te mantendrá libre de toxinas y sustancias nocivas innecesarias. La dieta mediterránea es ideal para mantener una buena salud.
Haz ejercicio con regularidad
No es necesario que hagas ejercicio durante muchas horas y de forma intensa. Con hacer unas cuantas horas de ejercicio a la semana a un ritmo suave son suficientes para que las funciones de tu cuerpo funcionen... ¡como un reloj!
No te pases con el alcohol
Debes de consumir alcohol siempre con moderación. No es necesario en todos los casos que te abstengas completamente de él, pero es importante mantener el consumo siempre con moderación.
En el caso de la ictericia neonatal, los consejos de prevención son diferentes. Se recomienda que alimentes a tu bebé con más frecuencia. Si le das el pecho debe de comer entre 8 y 12 veces al día durante los primeros días. En algunos casos, tu médico puede recomendar un suplemento de leche si tu pequeño está perdiendo peso y la leche materna no le es suficiente.
Preguntas frecuentes a los médicos sobre la ictericia
La ictericia en los adultos debe investigarse siempre a fondo, ya que suele enmascarar un problema sanguíneo o hepático. La ictericia neonatal no suele ser motivo de preocupación y a menudo ni siquiera necesita tratamiento, ya que se resuelve por sí sola. Si tu recién nacido tiene un color amarillo intenso, está somnoliento o muy inquieto, no come lo suficiente, pierde peso o tiene heces de colores extraños, debes ponerte en contacto con su pediatra inmediatamente.
Si un recién nacido presenta ictericia, la madre lactante debe amamantar al bebé incluso con más frecuencia (unas 8-12 veces al día). Si el bebé, con leche materna, presenta una pérdida de peso severa y la ictericia es elevada, puede ser necesario administrar leche extranjera como suplemento para reducir los niveles de bilirrubina.
Sí, en caso de que presentes niveles elevados de bilirrubina en la sangre puedes tener fiebre, náuseas, vómitos, pérdida de peso o incluso dolor pélvico. En cualquier caso, debes ponerte en contacto con un médico inmediatamente para recibir instrucciones sobre el mejor tratamiento para ti.
¿Tienes dudas? Habla con nuestros especialistas
Pregunta de forma anónima Pregunta gratis
Te enviaremos un correo electrónico cuando responda un especialista
Ha ocurrido un error inesperado. Por favor intenta nuevamente.
Envía una pregunta anónima
Moderamos tus preguntas y las enviamos a los especialistas de doctoranytime
Recibe actualizaciones para tu pregunta
Si ingresas tu correo electrónico, te avisaremos cuando un especialista responda a tu pregunta
Revisa las respuestas
Una vez que tu pregunta reciba una respuesta, la publicaremos en las secciones relacionadas de doctoranytime